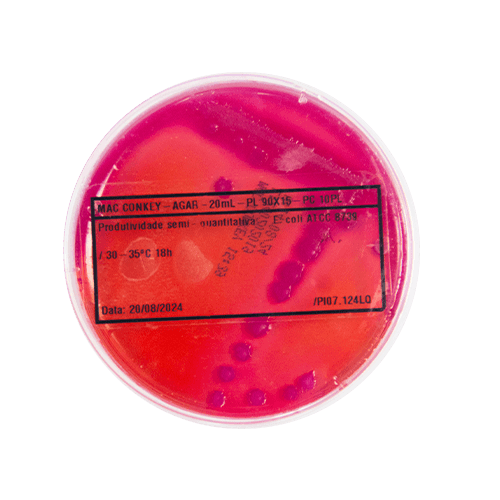

O ágar MacConkey é um meio de cultura seletivo e diferencial amplamente utilizado para isolamento e diferenciação de bactérias gram-negativas, especialmente enterobactérias. Sua aplicação abrange desde amostras clínicas, como fezes, urina e secreções, também no diagnóstico de infecções urinárias, gastrointestinais e outras doenças infecciosas, até o controle de qualidade em alimentos e água.